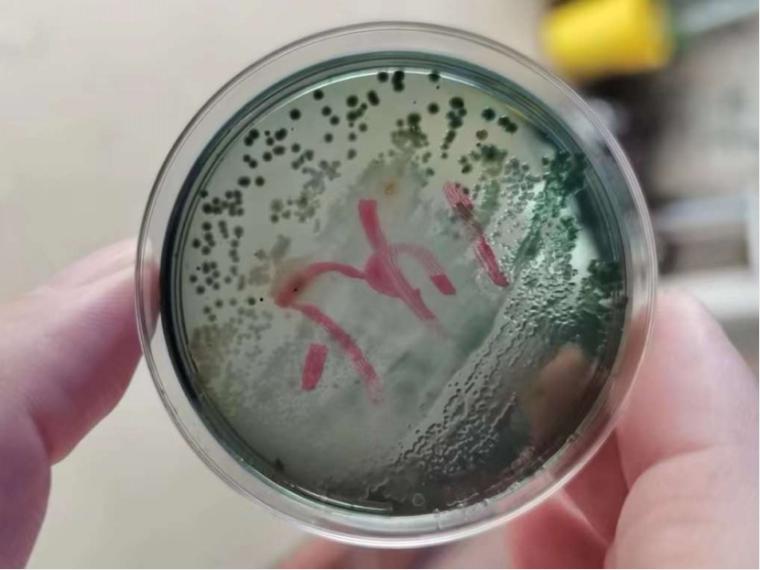

冬棚虾 养殖周期比正季要长半个月甚至1个月, 追规格就显得至关重要。缩短周期一是可以赶季出虾,效益好。二是减少养殖风险。大家普遍认为追规格就是多投料,但你有没有发现,有时候投料越多,反而长得越慢! 
冬棚大多数气温偏低, 对虾又是变温动物,分泌的消化酶数量少,活性差。除此之外, 饲料原料成本的增加倒逼一些饲料企业对配方进行微调,导致 饲料利用率差。投料过多对虾利用不了,就会以残饵粪便的形式排到水体当中,氨氮亚盐飙升往往也是跟这个原因,进一步影响对虾摄食,出现投料越多,长得越慢! 如何追规格,除了适当控料,还要注意以下几点 1、稳水、防病害 水的重要性不言而喻,勤测PH值、溶氧、氨氮、亚盐,多补有益菌,必要时借助化学制剂进行救急。如亚盐过高,可泼洒过硫+食盐+氧片。
主要关注弧菌、肝肠胞虫以及病毒病,设置蓄水池,对水质处理后再行排入养殖池;另外一定多注意细节,尤其病毒病、肝肠胞虫,传染非常迅速,进入养殖棚前一定对养殖工具、胶鞋等进行消毒。 2、护肝肠、促消化 内服胆汁酸+幸福100,搭配有益菌、多维多矿,促进对虾分泌更多的消化酶、提高消化酶活性。从而提高对饲料的利用率。 3、防应激、降损耗 根据养殖场景选择短时抗应激的VC或长效抗应激的幸福100,减少对虾应激。同时内服配合泼洒活力多(甲酸钙),抑菌的同时,补充对虾脱壳必需的钙,让对虾有足够的营养进行脱壳生长。 
冬棚虾追规格,你还有哪些好办法,欢迎留言讨论!
|